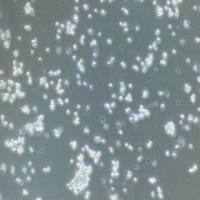
单核细胞

万千商家帮你免费找货
0 人在求购买到急需产品
- 详细信息
- 文献和实验
- 技术资料
- 品系:
/
- 细胞类型:
原代细胞
- 肿瘤类型:
/
- 供应商:
优利科(上海)生命科学有限公司
- 库存:
100
- 英文名:
无
- 生长状态:
/
- 年限:
/
- 运输方式:
快递形式
- 器官来源:
/
- 是否是肿瘤细胞:
/
- 细胞形态:
/
- 免疫类型:
/
- 物种来源:
人
- 相关疾病:
/
- 组织来源:
/
- 规格:
1×10⁶cells/T25培养瓶
人宫颈癌成纤维细胞
1.产品名称:人宫颈癌成纤维细胞
2.组织来源:宫颈癌组织
3.产品规格:5×105cells/T25细胞培养瓶
4.细胞简介:
人宫颈癌组织源成纤维细胞分离自患有宫颈癌病人的宫颈癌组织;宫颈癌也称子宫颈癌,指发生在子宫阴道部及宫颈管的恶性肿瘤,是女性常见恶性肿瘤之一,发病率位于女性肿瘤的第二位。宫颈癌可向邻近组织和器官直接蔓延,向下至阴道穹窿及阴道壁,向上可侵犯子宫体,向两侧可侵犯盆腔组织,向前可侵犯膀胱,向后可侵犯直肠。也可通过淋巴管转移至宫颈旁、髂内、髂外、腹股沟淋巴结,晚期甚至可转移到锁骨上及全身其他淋巴结。血行转移比较少见,常见的转移部位是肺、肝及骨。肿瘤微环境即肿瘤细胞生存的外部环境,由不同种类的非肿瘤性的细胞与细胞外基质(Extracellular matrix,ECM)构成,包括纤维细胞,免疫细胞,内皮细胞,间充质干细胞等,肿瘤细胞通过调控这些间质细胞,创造出有利于自身侵袭转移的条件,从而使得肿瘤得到进展。越来越多的证据表明,肿瘤微环境的改变在肿瘤进展中扮演着重要的角色。在肿瘤微环境中,研究最多也是最主要的间质细胞是肿瘤相关成纤维细胞(cancer-associated fibroblasts, CAFs)。CAFs 主要由肿瘤周边的正常成纤维细胞和成纤维细胞样细胞演化而来。宫颈癌组织源成纤维细胞多为突起的纺锤形或星形的扁平状结构,其细胞核呈规则的卵圆形,核仁大而明显。刚分离的宫颈癌组织源成纤维细胞呈圆形、折光性良好,悬浮于培养基中。30min细胞贴壁,其中部分开始伸出伪足,表现为小的突起;6h后细胞基本贴壁完全,伸展成梭形,胞核清晰,分布较均匀,散在生长,不聚集成团;细胞生长迅速,5-7天即呈融合状态,细胞排列紧密,有的交叉重叠生长,平坦、胞体较大,细胞质透明,细胞核较大,呈椭圆形,颜色淡。细胞融合,并彼此连接成网状;细胞呈突起的纺锤形或星形的扁平分布。
5.方法简介:
实验室分离的人宫颈癌成纤维细胞采用混合胶原酶消化法结合差速贴壁法制备而来,细胞总量约为5×10⁵cells/瓶。
6.质量检测:
实验室分离的人宫颈癌成纤维细胞经Vimentin免疫荧光鉴定,纯度可达90%以上,且不含有HIV-1、HBV、HCV、支原体、细菌、酵母和真菌等。
7.培养信息:
| 培养基 | 含FBS、生长添加剂、Penicillin、Streptomycin等 |
| 换液频率 | 每2-3天换液一次 |
| 生长特性 | 贴壁 |
| 细胞形态 | 成纤维细胞样 |
| 传代特性 | 可传5代左右;3代以内状态最佳 |
| 消化液 | 0.25%胰蛋白酶 |
| 培养条件 | 气相:空气,95%;CO2,5% |
人宫颈癌成纤维细胞体外培养周期有限;建议使用配套的专用生长培养基及正确的操作方法来培养,以此保证该细胞的最佳培养状态。

产品用途:
本产品只提供给进一步的科研使用,不可应用于治疗等其他方面。



风险提示:丁香通仅作为第三方平台,为商家信息发布提供平台空间。用户咨询产品时请注意保护个人信息及财产安全,合理判断,谨慎选购商品,商家和用户对交易行为负责。对于医疗器械类产品,请先查证核实企业经营资质和医疗器械产品注册证情况。
文献和实验早期治疗宫颈癌的关键在于早期诊断。目前常用的方法较多,亦有一些新的诊断方法不断被介绍和采用,但各有优缺点,必须互相配合应用以提高早期诊断率。 一、阴道细胞学检查 多年临床实践证明,阴道细胞学检查是发现早期宫颈癌的一个很有价值的方法。由于癌细胞代谢快,凝聚力差,容易脱屑,取材及检查方法简便,准确率高,目前已普遍作为宫颈癌普查筛选的首要方法。 有关阴道细胞学检查的标本采取、检查方法及癌细胞的特征等。 国内杨大望报告阴道细胞学诊断正确
丁香园网友hyong915的观点为:成纤维细胞培养(一) 原代培养1、在手术室无菌条件下,切取新鲜的皮肤,增殖性瘢痕和瘢痕疙瘩组织,修除表皮和皮下组织,盐水反复冲洗后放入含PS的DMEM培养液内带回无菌工作间。2、把组织块置于培养皿内,Hank,s液漂洗三遍后吸净Hank,s液,眼科剪反复剪切组织块成0.5-1mm3大小。用弯头吸管吸取组织块接种于40ml培养方瓶瓶壁上,组织块间留约0.3-0.5cm的间距。3、 塞好瓶塞,放入37℃电热恒温培养箱内3.5小时使培养的组织小块微干涸
通常宫颈癌的发展较慢,如能早期发现、早期诊断、早期治疗、手术和放疗治疗的效果比较肯定,其预后较其他系统癌症为好。 公认影响宫颈癌预后的重要因素包括肿瘤分级、盆腔淋巴结转移、浸润深度和淋巴血管间隙的侵犯。一般来说,越是晚期患者预后越差,累积资料表明,Ⅰ期患者5年存活率为75%~90%,Ⅱ期为50%~70%,Ⅲ期为30%~35%,Ⅳ期为10%~15%。 经过数十年的研究,虽然我国在宫颈癌的防治方面取得了显著的成绩,但回顾过去,展望未来,还有许多工作